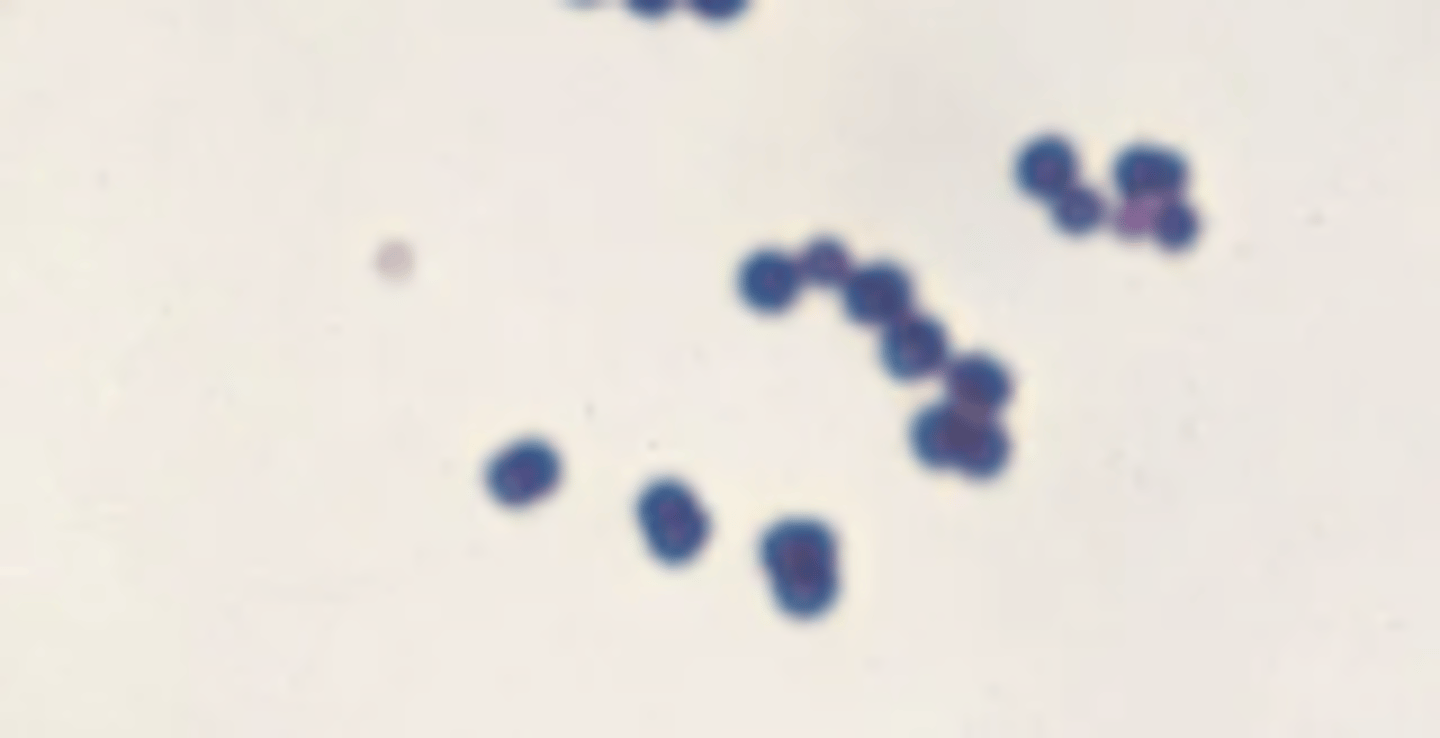
<p>Identify the bacteria's shape.</p>
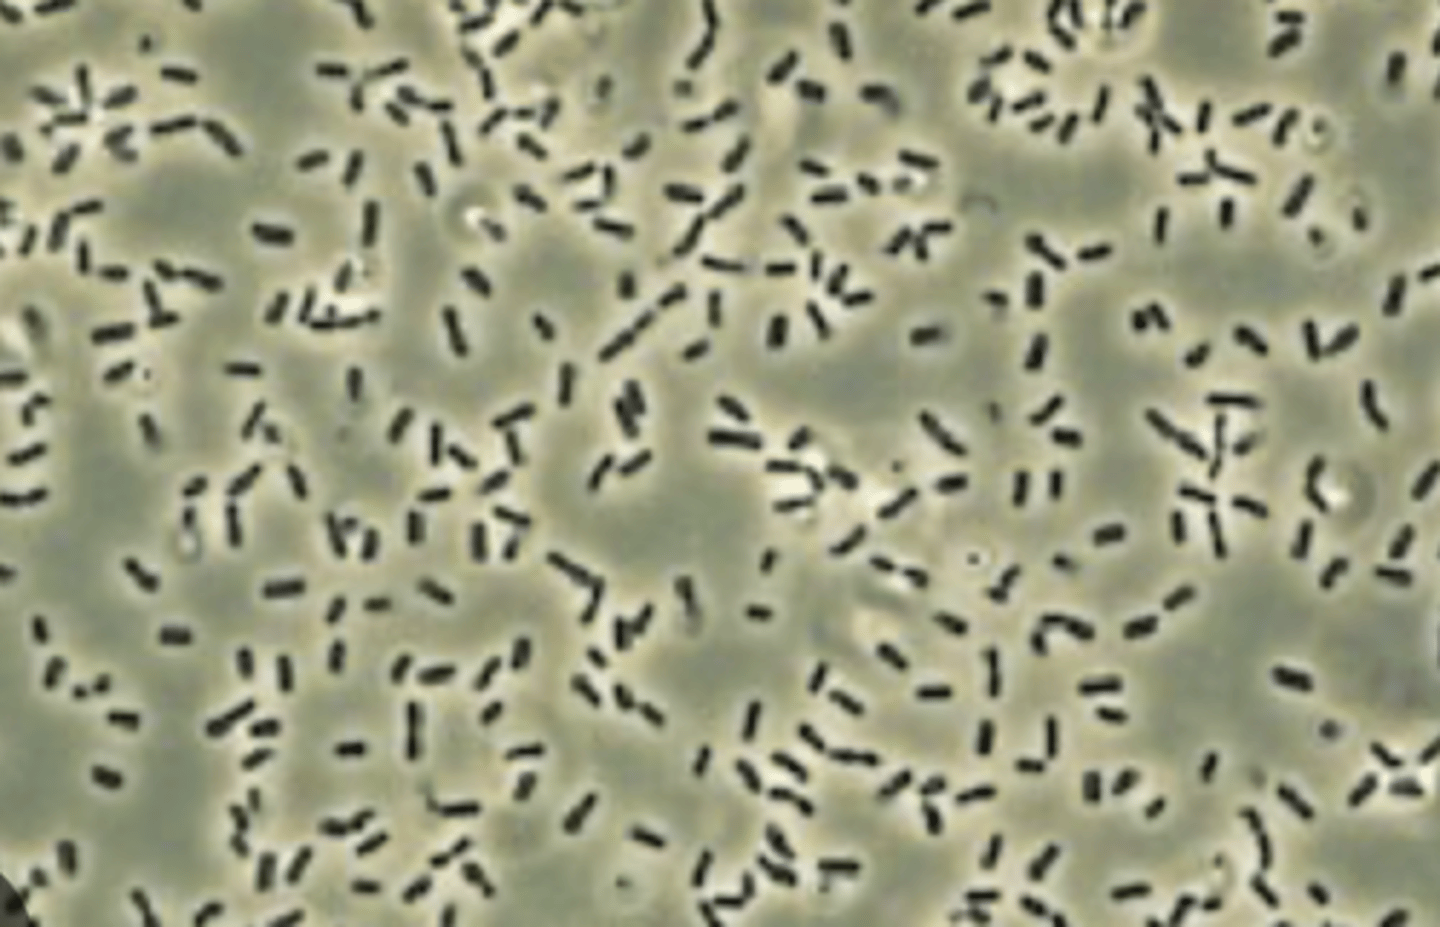
<p>Identify the bacteria's shape.</p>
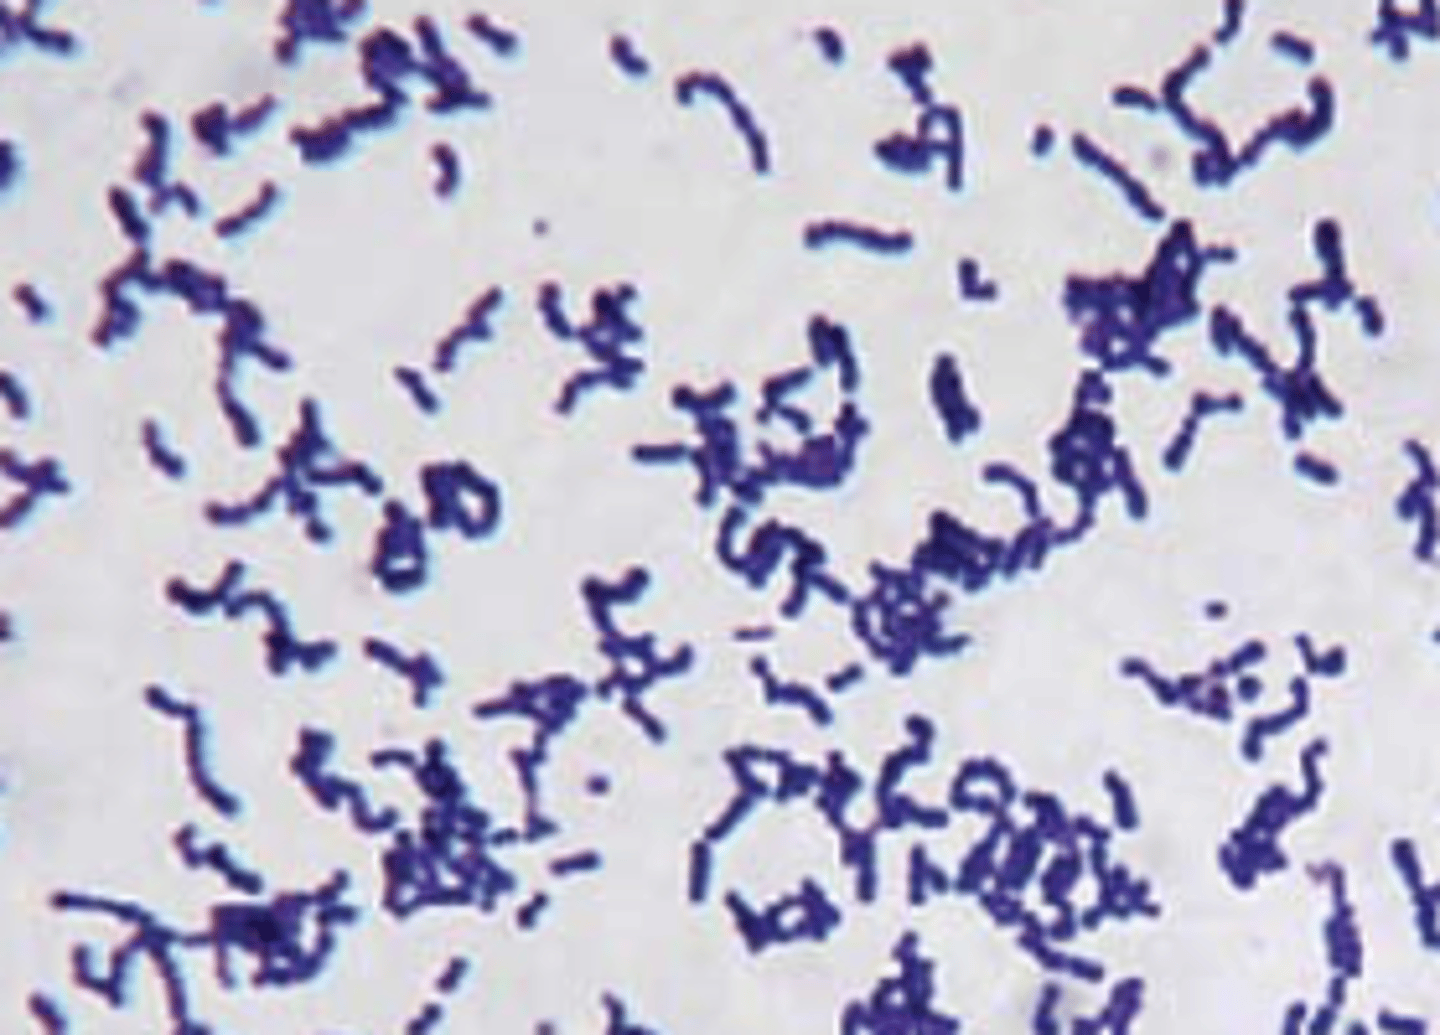
<p>Identify the gram-stain.</p>

1/125
Looks like no tags are added yet.
Name | Mastery | Learn | Test | Matching | Spaced | Call with Kai |
|---|
No analytics yet
Send a link to your students to track their progress
Antonie van Leeukwenhoek
Who discovered animalcules using early microscopy?
in rainwater
Where were the first observations of microscopic living creatures?
Viruses
Bacteria
Fungi
Parasites
What are the categories of microbes?
1. One organism, one disease
2. One organism, multiple disease manifestations
3. Multiple organisms, same disease
What are the microbial disease patterns?
one organism, one disease
Clostridium tetani causes tetanus is an example of?
One organism, multiple disease manifestations
Staphylococcus aureus causes skin infections, pneumonia, endocarditis, and osteomyelitis is an example of?
Multiple organisms, same disease
Meningitis can be caused by viruses, bacteria, fungi, and parasites is an example of?
3.9 × 10^13 colonizing microbes in human body
3.0 × 10^13 human cells
In the human microbiome, what is the number of microbes vs human cells?
microbes
Are there more human cells or more microbes in the human microbiome?
Skin and adjacent mucous membranes
Respiratory tract
Gastrointestinal tract ("Mouthville" - oral cavity)
Outer opening of urethra
External genitalia and vagina
External ear canal
External eye
Possibly blood
Where are the sites with normal microbiota?
shape
size
texture
What are the colony characteristics?
diplococci
Identify the bacteria's shape.
tetrads
Identify the bacteria's shape.

streptococci (chains)
Identify the bacteria's shape.

staphylococci (clusters)
Identify the bacteria's shape.

Bacillus (rod-shaped) single
Identify the bacteria's shape.
Bacillus (rod-shaped) chains
Identify the bacteria's shape.

Bacillus (rod-shaped) palisades
*palisades line up side by side
Identify the bacteria's shape.

Spirilla (spiral)
Identify the bacteria's shape.

Spirochetes (corkscrew)
Identify the bacteria's shape.

gram-positive (Positive=purple)
Identify the gram-stain.
gram-negative (negative=red)
Identify the gram-stain.

Biochemical tests (ex. mannitol fermentation)
PCR
What are some of the other identification methods besides gram-staining?
Single, double-stranded circular DNA in the nucleoid region
What is the structure of the bacterial chromosome?
Extrachromosomal DNA circles; confer advantages (antibiotic resistance)
What are plasmids?
plasmids
What cytoplasmic structures are involved in antibiotic resistance?
70s ribosome (30s and 50s subunits) which is different than the 80s eukaryotic
What ribosome is in bacteria?
70s ribosome (30s and 50s subunits) which is different than the 80s eukaryotic
What bacterial structure is good for drug targeting?
• Thick, multi-layered peptidoglycan
• Teichoic acid: linked to peptidoglycan, essential for viability
• Lipoteichoic acid: anchored in cell membrane, important for virulence
• May contain specific proteins (M protein in Streptococci, Protein A in S. aureus)
What are the characteristics of the Gram-positive cell wall?
• More complex structure with two layers
• Thin peptidoglycan layer
• Outer membrane with LPS (lipopolysaccharide)
• Periplasmic space: contains transport systems and enzymes
• Type III Secretion System: acts as molecular syringe to inject proteins into host cells
What are the characteristics of the Gram-negative cell wall?
linked to peptidoglycan in the cell wall and is essential for viability
What is teichoic acid?
Lipoteichoic acid
What part of the cell wall in gram-positive bacteria is anchored in the cell membrane and essential virulence?
gram positive
What type of cell has a thick, multilayered peptidoglycan cell wall?
Gram positive bacteria
What type of bacteria may contain specific proteins such as M and A proteins?
gram-negative
What type of bacteria has a thin peptidoglycan layer?
gram-negative
What type of bacteria has an outer membrane with LPS?
transport systems and enzymes
What is the periplasmic space used for?
acts as molecular syringe to inject proteins into host cells
What is a Type III secretion system?
gram-negative
What type of bacteria has a Type III secretion system?
1. Lipid A: Responsible for endotoxin activity
2. Core Polysaccharide: Necessary for structure and viability
3. O Antigen: Distinguishes serotypes
What are the three parts of the LPS?
Responsible for endotoxin activity
What is Lipid A for LPS (endotoxin) function?
Necessary for structure and viability
What is the core polysaccharide for LPS (endotoxin) function?
Distinguishes serotypes
What is the function of O antigen for LPS (endotoxin)?
- Powerful immune stimulator
- Causes fever, shock, DIC (disseminated intravascular coagulation)
- Binds to pattern recognition receptors (PRRs)
What is the clinical significance of LPS (endotoxin)?
- Waxy lipid coat of mycolic acid
- Antiphagocytic - important virulence factor
What type of cell wall does mycobacteria have?
- No peptidoglycan
- incorporate steroids from host into membranes
What type of cell wall do mycoplasmas have?
- Outer coating of polysaccharides and/or proteins
- Antiphagocytic - poorly antigenic
- Physical/chemical barrier
- Helps adherence to surfaces
What is the Capsule/Slime Layer/Glycocalyx for bacteria and what is the function?
- Composed of flagellin protein subunits (flagellin is a PAMP)
- Main function: motility
What is the flagella for bacteria and what is its function?
- Hair-like, composed of pilin subunits
- Smaller than flagella, usually several hundred per cell
- Promote adhesion - important virulence factor
- F pili (sex pili): for genetic transfer (conjugation)
What is the function of fimbriae and pili for bacteria and what is the function?
They are used for genetic transfer (conjugation)
What are F pili?
some gram-positive
What type of bacteria can form spores?
- Form under harsh conditions
- Can survive boiling and desiccation
- Become vegetative when conditions improve
What is the purpose of spore formation?
- eukaryotic organisms
- Cell wall made of chitin and glucan
- Cell membrane contains ergosterol (vs cholesterol in mammals) - drug target
- Main purpose: degrade organic material
What are the characteristics of fungi?
degrade organic material
What is the main purpose of fungi?
chitin and glucan
What are the cell walls of fungi made out of?
ergosterol (different than cholesterol in mammals)
What is in the cell membrane of fungi that is the target for drugs?
saprobes
What fungi decompose organic matter?
symbionts
What type of fungi hae mutualy benefical relationships?
commensals
What type of fungi benefit without harming the host?
parasites
What type of fungi cause disease?
Microorganism capable of causing disease
What is a pathogen?
False (minority)
T/F. Majority of microorganisms are pathogenic.
- Cause disease in immunocompromised individuals
- Normal (commensal) organism in wrong location (endogenous infection)
What is a opportunisitic pathogen?
- Quantitative measure of pathogenicity
- Related to toxigenic potential and invasiveness
What is virulence?
LD50: Number of organisms to kill 50% of hosts
ID50: Number needed to infect 50% of hosts
How is virulence measured by?
Number of organisms to kill 50% of hosts
What is LD50?
Number needed to infect 50% of hosts
What is ID50
spread host-to-host (e.g., tuberculosis via airborne droplets)
What does communicable mean?
not spread between hosts (e.g., staph food poisoning)
What is a noncommunicable disease?
non-communicable
Staph food poisoning is a non-communicable or communicable disease?
communicable
Tuberculosis via airborne droplets is a non-communicable or communicable disease?
highly
Contagious means ___________ communicable.
1. Incubation period
2. Prodromal period
3. Acute specific illness
4. Recovery
What are the steps to infectious disease?
Time between acquiring organism and start of symptoms (hours to weeks)
What is the incubation period for an infectious disease?
Nonspecific symptoms (fever, malaise)
What is the prodromal period?
Characteristic signs and symptoms
What is the acute specific illness period?
Illness subsides
Waht is the recovery period?
Subclinical infection: Without overt symptoms; may become chronic carriers
Latent state: Reactivation possible (e.g., HSV in trigeminal ganglion)
What are the special cases of the steps to infectious disease?
exogenous
What is the transmission route acquired from external source?
endogenous
What is the transmission route from normal organisms acting as opportunists?
1. Inhalation
2. Ingestion
3. Inoculation
What are the transmission methods?
airbone route
What is the inhalation method of transmission?
Fecal contamination of food/water
What is the ingestion method of transmission?
Sexual contact, needles, skin contact, transfusions, insect bites
What is the inoculation method of transmission?
- skin
- respiratory tract
- gastrointestinal
- genital tract
What are the portals of entry?
organisms must adhere to cause disease
What is the first step in an infection?
True
T/F. Mutants lacking adherence mechanisms often nonpathogenic
- Pili/Fimbriae
- Extracellular polysaccharides
- Afimbrial adhesins
What are some structures that facillitate attachment?
Degrades hyaluronic acid in connective tissue
What does hyaluronidase do?
Breaks down collagen
What does collagenase do?
Forms fibrin clot (S. aureus)
What does coagulase do?
Cleaves secretory IgA (major virulence factor at mucosal surfaces)
What does IgA protease do?
N. gonorrhoeae, H. influenzae, S. pneumoniae, periodontal pathogens
What is igA protease produced by?
leukocidins
What is an example of a toxin targeting immune cells?
Kill white blood cells
What are leukocidins?
- Acute response with neutrophil infiltration
- Predominates in acute periodontal abscess
What is Pyogenic (Pus-Forming) Inflammation?
- Chronic with macrophage/giant cell formation
- Associated with: Mycobacterium tuberculosis, fungi
What is Granulomatous Inflammation?
Pyogenic (Pus-Forming) Inflammation
What type of inflammation predominates with acute periodontal abscesses?
Granulomatous Inflammation
What type of inflammation is associated with mycobacterium tuberculosis and fungi?
True
T/F. Exotoxins are produced by both Gram-positive and Gram-negative bacteria